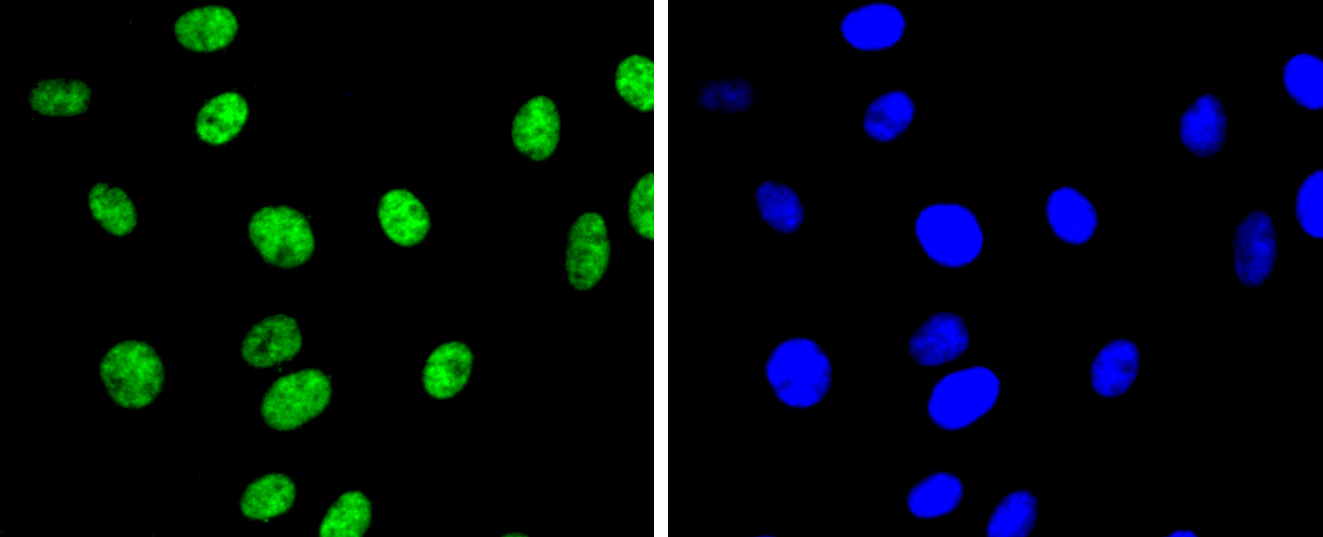
产品细节图片3
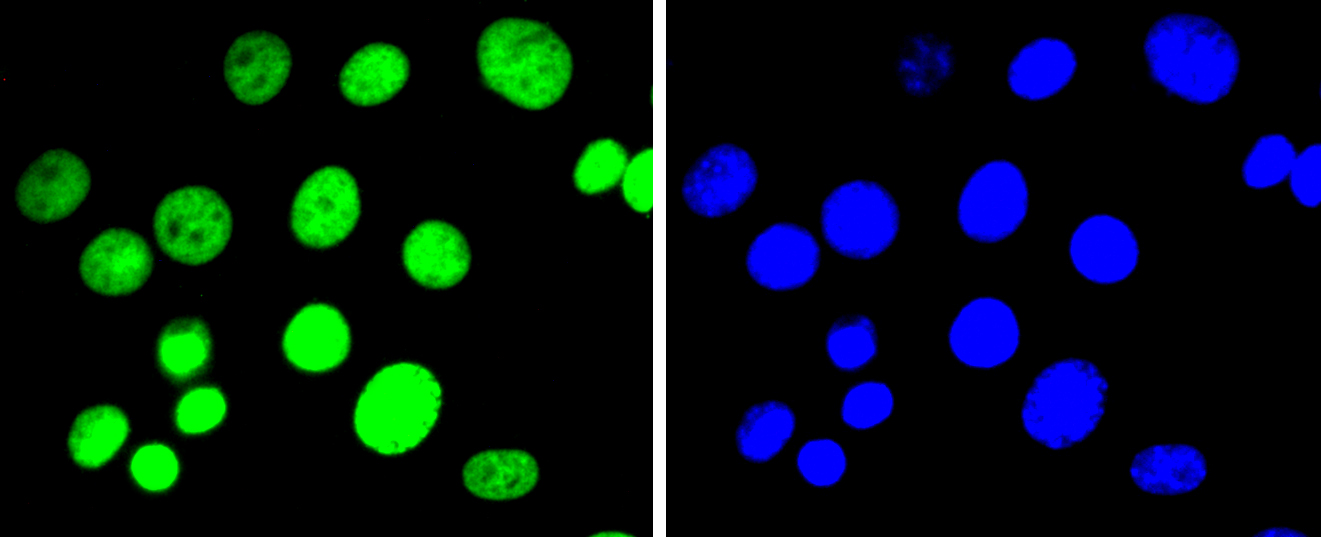
产品细节图片4

相关产品推荐更多 >
万千商家帮你免费找货
0 人在求购买到急需产品
- 详细信息
- 文献和实验
- 技术资料
- 免疫原:
recombinant protein
- 形态:
liquid
- 保存条件:
Store at -20˚C
- 克隆性:
Monoclonal
- 适应物种:
Human;Mouse;Rat
- 保质期:
12 months
- 抗原来源:
Recombinant Rabbit
- 供应商:
南京赛戈巍生物科技有限公司
- 宿主:
Recombinant Rabbit
- 应用范围:
WB, ICC/IF
- 靶点:
Uniprot:P68431
- 抗体英文名:
Histone H3(di methyl K9) Rabbit mAb
- 规格:
50ul/100ul
Histone gene cluster 1, H3 histone family, member E antibody
Histone gene cluster 1, H3G antibody
H3 histone family, member J antibody
HIST1 cluster, H3E antibody
HIST1 cluster, H3I antibody
Histone gene cluster 1, H3C antibody
FLJ92264 antibody
H3 histone family, member A antibody
H3 histone family, member B antibody
H3 histone family, member C antibody
H3 histone family, member D antibody
H3 histone family, member F antibody
H3 histone family, member H antibody
H3 histone family, member I antibody
H3 histone family, member K antibody
H3 histone family, member L antibody
H3 histone family, member T antibody
H3 histone, family 3A antibody
H3.1 antibody
H3.3A antibody
H3/a antibody
H3/b antibody
H3/c antibody
H3/d antibody
h3/f antibody
H3/h antibody
H3/i antibody
H3/j antibody
H3/k antibody
H3/l antibody
H3/t antibody
H31_HUMAN antibody
H3F1K antibody
H3F3 antibody
H3F3A antibody
H3FA antibody
H3FB antibody
H3FC antibody
H3FD antibody
H3FF antibody
H3FH antibody
H3FI antibody
H3FJ antibody
H3FK antibody
H3FL antibody
HIST1 cluster, H3A antibody
HIST1 cluster, H3B antibody
HIST1 cluster, H3C antibody
HIST1 cluster, H3D antibody
HIST1 cluster, H3F antibody
HIST1 cluster, H3G antibody
HIST1 cluster, H3H antibody
HIST1H3A antibody
HIST1H3B antibody
HIST1H3C antibody
HIST1H3D antibody
HIST1H3E antibody
HIST1H3F antibody
HIST1H3G antibody
HIST1H3H antibody
HIST1H3I antibody
HIST1H3J antibody
HIST3H3 antibody
Histone 1, H3a antibody
Histone 1, H3b antibody
Histone 1, H3c antibody
Histone 1, H3d antibody
Histone 1, H3e antibody
Histone 1, H3f antibody
Histone 1, H3g antibody
Histone 1, H3h antibody
Histone 1, H3i antibody
Histone 1, H3j antibody
histone 3, H3 antibody
histone cluster 1 H3 family member a antibody
histone cluster 1 H3 family member b antibody
histone cluster 1 H3 family member c antibody
histone cluster 1 H3 family member d antibody
histone cluster 1 H3 family member e antibody
histone cluster 1 H3 family member f antibody
histone cluster 1 H3 family member g antibody
histone cluster 1 H3 family member h antibody
histone cluster 1 H3 family member i antibody
histone cluster 1 H3 family member j antibody
Histone cluster 1, H3a antibody
Histone cluster 1, H3b antibody
Histone cluster 1, H3c antibody
Histone cluster 1, H3d antibody
Histone cluster 1, H3e antibody
Histone cluster 1, H3f antibody
Histone cluster 1, H3g antibody
Histone cluster 1, H3i antibody
Histone cluster 1, H3j antibody
Histone gene cluster 1, H3 histone family, member A antibody
Histone gene cluster 1, H3 histone family, member B antibody
Histone gene cluster 1, H3 histone family, member C antibody
Histone gene cluster 1, H3 histone family, member D antibody
Histone gene cluster 1, H3 histone family, member F antibody
Histone gene cluster 1, H3 histone family, member G antibody
Histone gene cluster 1, H3 histone family, member H antibody
Histone gene cluster 1, H3 histone family, member I antibody
Histone gene cluster 1, H3 histone family, member J antibody
Histone gene cluster 1, H3A antibody
Histone gene cluster 1, H3B antibody
Histone gene cluster 1, H3D antibody
Histone gene cluster 1, H3E antibody
Histone gene cluster 1, H3F antibody
Histone gene cluster 1, H3H antibody
Histone gene cluster 1, H3I antibody
Histone gene cluster 1, H3J antibody
Histone H 3 antibody
Histone H3.1 antibody
histone H3.1t antibody
Histone H3.2 antibody
Histone H3/a antibody
Histone H3/b antibody
Histone H3/c antibody
Histone H3/d antibody
Histone H3/f antibody
Histone H3/h antibody
Histone H3/i antibody
Histone H3/j antibody
Histone H3/k antibody
Histone H3/l antibody
Histone H3/m antibody
Histone H3/o antibody
计算分子量:15 kDa
配方:1*TBS (pH7.4), 1%BSA, 40%Glycerol. Preservative: 0.05% Sodium Azide.
应用详情:WB: 1:1,000
ICC: 1:100-1:500
图片:

ICC staining Histone H3(di methyl K9) in HepG2 cells (green). The nuclear counter stain is DAPI (blue). Cells were fixed in paraformaldehyde, permeabilised with 0.25% Triton X100/PBS.
,

ICC staining Histone H3(di methyl K9) in Hela cells (green). The nuclear counter stain is DAPI (blue). Cells were fixed in paraformaldehyde, permeabilised with 0.25% Triton X100/PBS.
,
ICC staining Histone H3(di methyl K9) in L6 cells (green). The nuclear counter stain is DAPI (blue). Cells were fixed in paraformaldehyde, permeabilised with 0.25% Triton X100/PBS.
,
ICC staining Histone H3(di methyl K9) in NIH/3T3 cells (green). The nuclear counter stain is DAPI (blue). Cells were fixed in paraformaldehyde, permeabilised with 0.25% Triton X100/PBS.
风险提示:丁香通仅作为第三方平台,为商家信息发布提供平台空间。用户咨询产品时请注意保护个人信息及财产安全,合理判断,谨慎选购商品,商家和用户对交易行为负责。对于医疗器械类产品,请先查证核实企业经营资质和医疗器械产品注册证情况。
文献和实验Competing Chromosomal Proteins from Drosophila Polytene Chromosomes Using Modified Histone Peptides
to chromatin, by its histone tail interaction or by other interactions, then you would not expect to see loss of binding upon peptide competition. A good positive control for the assay is to use H3K9 dimethylated peptide to compete HP1 from the pericentric
Installation of Site‐Specific Methylation into Histones Using Methyl Lysine Analogs
aminoethylcysteine, an isosteric analog of methyl lysine. Using different alkylating reagents, it is possible to install analogs of mono?, di?, or trimethyl lysine. While these analogs are not identical to methyl lysine residues, they show similar biochemical
浅析染色质免疫沉淀(ChIP)技术在 DNA 与蛋白质相互作用研究中的重要性
因子的结合位置。 ChIP 是染色质结构改变,特别是组蛋白修饰后,研究全基因组活化或抑制作用的少数工具之一。ChIP 可以针对乙酰化或者甲基化的组蛋白,富集该区域的 DNA ,因此可以进行基因组的多样性分析。2008 年,Xiang 等人 [7] 发现硒(Se)处理与前列腺癌细胞的 DNA 甲基化水平降低、组蛋白乙酰化水平升高、GSTP1(前列腺癌相关蛋白)活化有关。试验中,他们用 ChIP 技术富集了乙酰化 H3-k9 和甲基化 H3-K9,对分离获得的 DNA 进行多个基因的 PCR 扩增
技术资料暂无技术资料 索取技术资料





![ALG2 Rabbit Polyclonal Antibody[55343]](https://img1.dxycdn.com/p/s14/2025/0922/498/0460884283108299691.jpg!wh200)
![ATPase Conjugated Antibody[C29094]](https://img1.dxycdn.com/p/s14/2025/0923/278/4431488150116040791.jpg!wh200)


